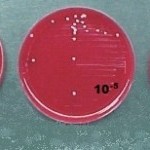
Imagem 1
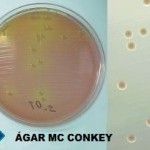
Imagem 4

Caso nº 3
Caso Clínico #5
Local: Curitiba-PR
Mês / Ano: Abril/2001
Assuntos relacionados: Pneumonia nosocomial. Sexo masculino.
Quadro Clínico
Paciente do sexo masculino, 25 anos, vítima de acidente automobilístico, foi admitido no hospital com politraumatismo (craniano, esplênico, e múltiplas fraturas nos membros), hipotensão profunda e hemorragia interna. Foi intubado e tratado com papa de hemácias e fluidos intravenosos. Permaneceu intubado e dependente de ventilação mecânica por 4 semanas. Apresentou febre e foi tratado com antibióticos de largo espectro. Como não apresentou melhora do quadro infeccioso, foi coletado após vários dias de tratamento antibiótico um aspirado traqueal sanguinolento cujo crescimento em ágar-sangue pode ser visualizado nas placas disponíveis na imagem 1.
Com base nos dados clínicos e laboratoriais, propomos as seguintes questões para discussão do caso:
Com base no quadro clínico e nos dados laboratoriais, sugerimos as seguintes questões para discussão do caso.
1) Qual o provável diagnóstico deste paciente?
2) Em um caso como este, qual o tipo de bactéria suspeito?
3) Como deveria ser feito o diagnóstico laboratorial deste tipo de infecção?
4) Quais os fatores de risco apresentados pelo paciente que favorecem a colonização por este tipo de bactéria?
5) Por que é importante diagnosticar e tratar precocemente estas infecções?
6) Como seria possível tratar empiricamente o paciente com a máxima possibilidade de acerto na escolha do antibiótico?
7) Qual a melhor forma de coleta do material clínico para exame bacteriológico?
8) Como deve ser o processamento primário deste tipo de amostra?
9) Como deve ser interpretada a cultura ilustrada acima?
10) Observando o resultado das provas nas imagens 2 a 7, qual a provável bactéria isolada?
11) Quais as antigas denominações desta bactéria?
12) Tendo em vista o perfil de suscetibilidade disposto nos dados laboratoriais, como poderia ser tratada esta infecção?
13) Quais os possíveis mecanismos de resistência apresentados por esta bactéria?
14) Considerando os dois hemogramas, dispostos nos dados laboratoriais, que interpretação pode ser feita do eritrograma?
15) Este paciente apresenta um quadro leucêmico ou uma reação leucemóide?
16) Qual o significado do aparecimento de granulações tóxicas, corpúsculos de Döhle e vacúolos no citoplasma dos neutrófilos?
17) Como a trombocitopenia deve ser interpretada?
Referências Bibliográficas
SILVA, P. H. & HASHIMOTO, Y. Interpretação Laboratorial do Eritrograma. São Paulo, Ed. Lovise, 1999.
PILONETTO, M. & PILONETTO, D.V. Manual de procedimentos laboratoriais em Microbiologia. Curitiba, Ed. Microscience, 1998.
UNIVERSIDADE FEDERAL DO PARANÁ. Manual do Laboratório. Curitiba, Hospital de Clínicas, 1990.
MAHON, C.R. & MANUSELIS Jr., G. Textbook of Diagnostic Microbiology. Philadelphia, W.B. Saunders Company, 1995.
MILLER, J.M. A Guide to Specimen Management in Clinical Microbiology. Washington, ASM Press, 1996.
NATIONAL COMMITTEE FOR CLINICAL LABORATORY STANDARDS. Performance Standards for Antimicrobial Disk Susceptibility Tests. Approved standard M2-A7. Wayne, NCCLS, 2000.
KONEMAN, E.W. et al. Color Atlas and Textbook of Diagnostic Microbiology. 5th Ed. Philadelphia, Lippincott, 1997.
MURRAY, P.R. Manual of Clinical Microbiology. 7th Ed. Washington, ASM Press, 1999.
OPLUSTIL, C.P.; ZOCCOLI, C.M.; TOBOUTI, N.R.; SINTO, S.I. Procedimentos Básicos em Microbiologia Clínica. São Paulo, Sarvier, 2000.
Dados Laboratoriais
Diâmetro dos halos de suscetibilidade
Amicacina = 12 mm
Ampicilina/Sulbactam = 18 mm
Cefepime = 0 mm
Cefpirome = 0 mm
Ceftazidima = 0 mm
Ceftriaxona = 0 mm
Ciprofloxacin = 0 mm
Gentamicina = 0 mm
Imipenem = 30 mm
Penicilina = 0 mm
Piperacilina/Tazobactam = 13 mm
Polimixina B = 15 mm
Sulfametoxazol/Trimetoprim = 0 mm
1° Hemograma
Eritrócitos 3.660.000 / mL
Hemoglobina 11,7 g / dL
Volume globular 34,3%
VCM 93,7 fL
HCM 31,9 pg
CHCM 34,1 %
Leucócitos 34.300 / mL
Mielócitos 2%
Metamielócitos 2%
Bastonetes 67%
Segmentados 26%
Eosinófilos 0%
Linfócitos 2%
Monócitos 1%
Plaquetas 132.000 / mL
Anisocitose + Pecilocitose + Policromatofilia + Granulações tóxicas ++ Vacúolos + Corpúsculos de Döhle +
2° Hemograma
Eritrócitos 3.310.000 / mL
Hemoglobina 10,5 g / dL
Volume globular 30,8%
VCM 93,0 fL
HCM 31,7 pg
CHCM 34,0%
Leucócitos 27.400 / mL
Mielócitos 0%
Metamielócitos 1%
Bastonetes 75%
Segmentados 19%
Eosinófilos 0%
Linfócitos 4%
Monócitos 1%
Plaquetas 112.000 / mL
Anisocitose + Pecilocitose + Policromatofilia ++ Micrócitos + Macrócitos + Granulações tóxicas + Vacúolos + Corpúsculos de Döhle +
Respostas da discussão
1) Pneumonia nosocomial associada a ventilação mecânica.
2) Devido ao longo tempo de permanência no hospital, o tipo de bactéria mais provável é bacilo gram negativo multirresistente.
3) Cultura quantitativa de secreção traqueal e hemocultura.
4) Estado geral grave, tratamento prévio com antibióticos de largo espectro e intubação prolongada com ventilação mecânica.
5) A pneumonia por bacilos gram negativos é a principal causa de morte devido a infecção hospitalar.
6) Pela análise de relatórios estatísticos dos bacilos gram negativos mais comuns naquele hospital e seus perfis de suscetibilidade.
7) Material obtido com sonda de aspiração em tubo tipo "Luken’s trap".
8) O material deve ser homogeneizado com um fluidificante tipo ditiotreitol ou fluimucil, diluído seriadamente até 10-7 ou 10-8 e semeado nas diluições mais altas em meios apropriados (ágar sangue, ágar Mac Conkey e ágar chocolate).
9) Cultura positiva para BGN (Bacilos gram negativos) com contagem de colônias superior a 106/mL.
10) Acinetobacter baumannii.
11) Acinetobacter calcoaceticus var. anitratus, Achromobacter anitratus, Bacterium anitratum, Herellea vaginicola, bacilo Morax-Axenfeld, Pseudomonas calcoacetica.
12) Ampicilina/Sulbactam ou Imipenem.
13) Produção de beta-lactamases e enzimas modificadoras de aminoglicosídeos.
14) O paciente apresenta uma anemia moderada no primeiro hemograma, a qual persiste no segundo hemograma, apesar da transfusão sangüínea. Isto é sinal de que a hemorragia interna continua (traumatismo esplênico). A anemia é normocítica e normocrômica e causada pela hemorragia. O segundo hemograma mostra uma policromatofilia mais acentuada, o que significa que a medula óssea está com sua produção eritrocitária aumentada, em razão da perda sangüínea.
15) Se fosse um quadro leucêmico deveria se pensar em leucemia mielóide crônica, porém a causa das alterações leucocitárias (paciente politraumatisado) não indicam uma LMC. O aparecimento de granulações tóxicas, vacúolos e corpúsculos de Döhle indica um processo infeccioso grave. Se houvesse alguma dúvida quanto a possibilidade de ser uma LMC, deveria ser feito uma prova citoquímica de fosfatase alcalina. A FAL apresenta um "score" aumentado nos processos infecciosos e baixo na LMC. A trombocitopenia não indica LMC. Por definição, o paciente tem uma reação leucemóide quando o número de leucócitos está acima de 50.000 / microlitro.
16) Este quadro leucocitário é característico de um quadro infeccioso agudo e grave. Só o fato do paciente estar politraumatisado explicaria a leucocitose e o desvio à esquerda. A associação da leucocitose com desvio até mielócitos, granulações tóxicas, corpúsculos de Döhle e vacúolos, caracteriza um processo infeccioso agudo. A presença de vacúolos no citoplasma dos neutrófilos deve ser interpretada como atividade fagocitária, a passagem de alguma bactéria pela corrente circulatória (bacteremia) ou que o paciente está apresentando um quadro de septicemia.
17) A trombocitopenia indica para septicemia. A toxina bacteriana está fazendo lesão em células endoteliais (células que revestem a luz do vaso sangüíneo) as quais agregam plaquetas. Ocorre o consumo de plaquetas na corrente circulatória, pode haver ativação dos fatores de coagulação e o paciente pode ainda desencadear uma coagulação intravascular disseminada.